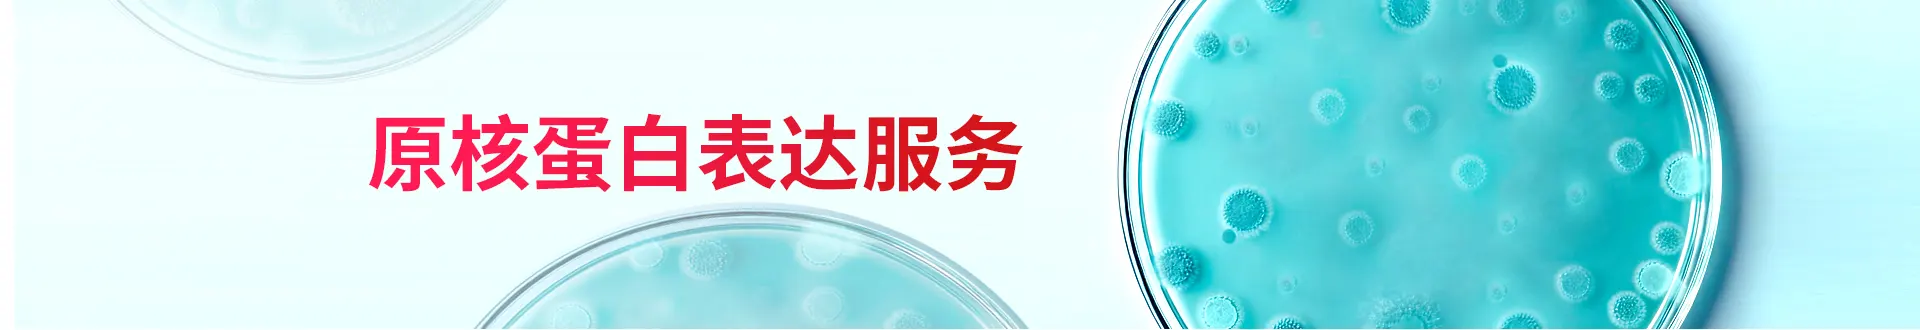

大肠杆菌表达系统是基于大肠杆菌(Escherichia coli)宿主的高效表达重组蛋白生物学技术,是目前应用最广的蛋白表达系统。其核心优势包括遗传背景清晰、生长周期短、成本低廉,且能实现外源蛋白的高表达量。
Elabscience® 提供从密码子优化、基因合成、载体构建到蛋白质表达和纯化的一站式服务,也可根据客户要求进行包涵体纯化及复性等服务。
在线咨询原核蛋白表达服务服务优势
标签多元
涵盖Trx、GST、MBP、Sumo、HA、Flag、His等
载体多样
涵盖pET-28a、pET-32a、pET-42a、pET-22b等
低内毒素
内毒素< 10 EU/mg
成熟体系
依托标准化流程,已交付2,000+项目
服务内容
周期:4-6周
基因合成
1周
目的基因合成及密码子优化


载体构建
1周
克隆至表达载体
质粒测序
质粒制备


小量表达及纯化
2周
大肠杆菌表达体系-100 mL
蛋白纯化
蛋白质检:SDS-PAGE


大规模表达和纯化(可选)
2周
1 L表达体系或者更多
蛋白纯化
蛋白质检:SEC-HPLC、SDS-PAGE、WB、ELISA(可选)


交付内容
重组表达蛋白
项目报告

案例展示
案例1 靶蛋白A
载体:pET-32
标签:Trx & His
浓度:1 mg/mL
纯度:>95%

SDS-PAGE分析
案例2 靶蛋白B
载体:pET-28a
标签:His
浓度:0.6 mg/mL
纯度:>90%

SDS-PAGE分析
案例3 靶蛋白C
载体:pET-32
标签:Trx & His
浓度:0.8 mg/mL
纯度:>95%

SDS-PAGE分析
在线咨询原核蛋白表达服务
我们的技术支持会在收到需求表后第一时间与您联系,并根据您的需求提供专业的服务,您所填写的信息会被严格保密,敬请放心填写。
